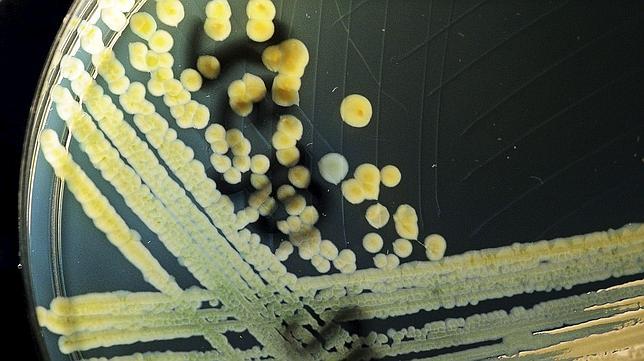
Una epidemia causada por una bacteria intestinal desata las alarmas en Alemania

Una epidemia causada por una bacteria intestinal desata las alarmas en Alemania
La «Escherichia coli», que ya ha dejado una víctima y más de 300 casos sospechosos, puede provocar diarreas sangrientas en los episodios más graves
EFE
Una mujer de 83 años es la primera víctima mortal de un brote epidemiológico de la bacteria intestinal «Escherichia coli» y su cepa «O157:H7», que se extiende por Alemania de norte a sur y que ha hecho decretar la alerta sanitaria.
Las autoridades han registrado hasta el momento mas de 300 casos sospechosos , la mayoría en el norte del país, con mas de 40 enfermos hospitalizados en estado grave , mientras los responsables sanitarios tratan de averiguar el foco de la epidemia.
La citada bacteria puede provocar en los casos mas graves diarreas sangrientas , causa de la muerte de la anciana en el estado de la Baja Sajonia, según anunció hoy el Ministerio de Sanidad de ese Land en Hannover, en el norte del país.
Los enfermos más graves se encuentran afectados por un síndrome urémico hemolítico (SUH), que se caracteriza por insuficiencia renal, anemia hemolítica microangiopática, trombocitopenia, defectos de la coagulación y signos neurológicos variables.
Una bacteria resistente a los antibióticos
Al parecer se trata de una cepa de la bacteria «Escherichia coli» de alta resistencia a los antibióticos, lo que dificulta el tratamiento, y que afecta principalmente a mujeres y niños.
El Instituto Robert Koch de Berlín ha informado de que s u origen podría estar en verduras que podrían haber resultado contaminadas con estiércol líquido usado para abonos y no descarta que el foco continúe activo.
Tampoco se descarta que los afectados hayan enfermado por la ingestión de productos lácteos o carnes semicrudas , ya que la cocción de los alimentos mata inmediatamente la bacteria y evitan su contagio.
Las autoridades sanitarias alemanas han informado de que los primeros casos se registraron a mediados de este mes en la Baja Sajonia, Bremen, Hamburgo y Schleswug-Holstein, todos ellos estados en el norte de Alemania, aunque comienzan a detectarse posibles contagios en Hesse, Renania del Norte-Westfalia y Mecklemburgo Antepomerania, que lindan con los primeros.
Esta funcionalidad es sólo para suscriptores
Suscribete
Esta funcionalidad es sólo para registrados
Iniciar sesiónEsta funcionalidad es sólo para suscriptores
Suscribete